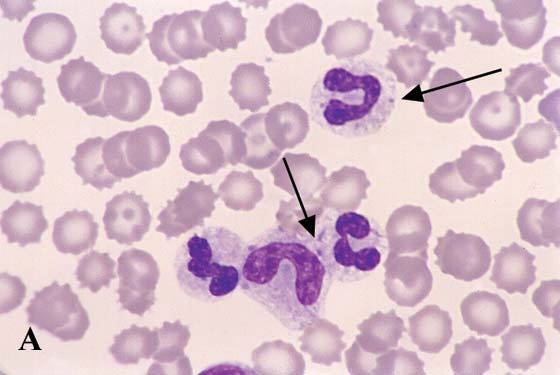

RBC validity
<25
WBC validity
<15
RBC total in macroliters
WBC total in macroliters
Average of chambers x 1,000 / 9
Platelet total
Average of 10 random fields x 15,000
MCV
PCV x 10 / Hemoglobin count
MCH
Hemoglobin x 10 / RBC count
MCHC
Hemoglobin x 100 / PCV
Reticulocyte count
WBC Corrected count

Band cell
Toxic neutrophil

Neucleated RBC

Reticulocyte